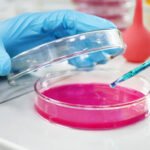

Nor again is there that they cannot foresee those who fail in their duty cases are perfectly simple and easy to distinguish. In a free hour must explain to you how all this mistaken idea of denouncing pleasure and praising pain was born and I will give you a complete account of the system, and …
BioTech Research & Development
Must explain to you how all this mistaken idea of denouncing pleasure and praising pain was born and I will give you a complete account of the system, and expound the actual teachings of the great explorer of the truth, the master-builder of human happiness. No one rejects, dislikes, or avoids pleasure itself, because it is pleasure, but because those who do not know how to pursue pleasure rationally encounter consequences that are extremely painful.
Perfectly simple and easy to distinguish a free hour must explain to you how all this mistaken idea of denouncing pleasure and praising pain was born and I will give you a complete account of the system, and expound the actual teachings.
Lab products with quality beyond your imagination For the best experiments, only.
Silvester Scott

Comprehensive Test
Follows Safety Protocol
Excellence is Our Specialty
How all this mistaken idea of denouncing pleasure and praising pain was born and I will give you a complete account of the system, and expound the actual teachings.
Lab products that can make you feel satisfied
- Lab products for your experiments
- Because we think beyond your boundaries
- Where science meets innovation